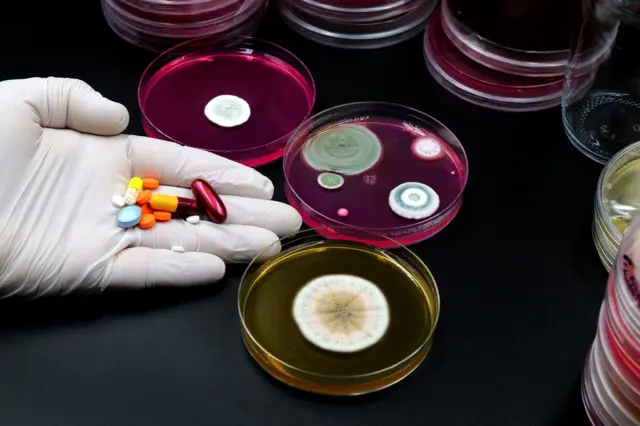
Mano llena de medicamentos al lado de unas muestras de bacterias en un laboratorio.

Cómo Darwin y la teoría de la evolución están cambiando la medicina

Fuente de la imagen, Getty Images
- Autor, Sofia Quaglia
- Título del autor, BBC Future
Cuando tenía 20 años, Randolph Nesse se preguntó por qué envejecemos. No podía entender por qué la selección natural no había eliminado el envejecimiento por completo. Esto sentó las bases de una forma completamente nueva de pensar la medicina.
Años más tarde, amigos de un museo de historia natural local señalaron a Nesse la teoría de que el envejecimiento es simplemente un efecto secundario de la presión evolutiva que selecciona unos genes sobre otros. Si una afección sólo se manifiesta después de que un organismo supera su pico reproductivo, entonces no habrá presión selectiva para evitar que se transmita.
Como médico, Nesse se dio cuenta de que, si bien entendía cómo estas fuerzas podían dar forma a las especies, no tenía ni idea de cómo funcionaba la selección natural dentro del cuerpo humano.
"Nadie había hablado nunca de la importancia de la biología evolutiva (en la medicina). Inmediatamente comencé a preguntarme si había explicaciones similares para los genes que causan las enfermedades".
A Nesse se le atribuye ahora el mérito de ser el padre fundador de la medicina evolutiva, a veces también conocida como medicina darwiniana, una disciplina relativamente nueva y en crecimiento que aplica la teoría de la evolución a cuestiones sobre la salud y las enfermedades humanas.
Si bien la mayoría de las investigaciones médicas modernas se centran en las causas físicas y moleculares de las enfermedades, la medicina evolutiva intenta comprender por qué podríamos haber evolucionado para ser susceptibles a las enfermedades en primer lugar, y cómo podemos utilizar la evolución para combatirlas.

Fuente de la imagen, Getty Images
"Lo que estamos tratando aquí es una ciencia básica completamente nueva que no se ha aplicado a la medicina", dice Nesse.
Es una empresa muy grande cambiar completamente lo que pensamos sobre qué es el cuerpo humano y cómo funciona. Su trabajo ya está empezando a cambiar nuestra comprensión de cómo se desarrollan los cánceres y las enfermedades autoinmunes.
También está revelando nuevas estrategias para abordar problemas perniciosos relacionados con la atención sanitaria, como la resistencia a los antimicrobianos.
"Me ha sorprendido que haya habido tantas implicaciones prácticas en tan poco tiempo", dice Nesse.
Un nuevo modo de entender el cáncer
Los cánceres son en sí mismos una demostración del proceso evolutivo en un microcosmos. Son grupos de células que compiten y cooperan continuamente entre sí de manera que ayudan al tumor a crecer y florecer.
Un estudio reciente destacó la capacidad casi "infinita" de las células cancerosas para evolucionar y sobrevivir.
Cuando un paciente recibe terapia farmacológica, por ejemplo, se introduce una nueva presión selectiva que elimina las células que son más vulnerables al tratamiento. Aquellas que son menos vulnerables, o incluso inmunes a los efectos del tratamiento, sobreviven para transmitir sus rasgos genéticos a las células que las siguen.
Es por eso que incluso las terapias contra el cáncer que han tenido éxito con el tiempo dejarán de funcionar en muchos pacientes: las células cancerosas desarrollan resistencia al tratamiento y luego aumentan incontrolablemente.
"Podríamos justificar que esta sea la causa inmediata de muerte en la mayoría de los pacientes", afirma Robert Gatenby, codirector del Centro de Excelencia para la Terapia Evolutiva del Moffitt Cancer Center, en Florida, EE.UU.
A través de la lente del pensamiento evolutivo, el laboratorio de Gatenby está desarrollando dos estrategias diferentes para abordar el cáncer: terapia adaptativa y terapia de extinción.
La terapia adaptativa tiene como objetivo controlar la propagación del cáncer en lugar de intentar eliminarlo por completo.
El dogma durante los últimos 50 años en el tratamiento del cáncer ha sido que se aplica el mismo medicamento, o combinación de medicamentos, en ciclos, hasta que haya evidencia clara de progresión del tumor (donde el tumor comienza a crecer sin control) o exceso de toxicidad, dice Gatenby, lo cual suele ocurrir mucho después de que se haya obtenido la máxima respuesta.

Fuente de la imagen, Getty Images
Esto es "inútil", afirma, ya que la mayoría de las células que quedan son resistentes al fármaco y al continuar con la misma terapia, el oncólogo les da la oportunidad de proliferar para que su población sea mayor y más diversa.
Su teoría de la terapia adaptativa, por el contrario, apunta a ajustar la dosis de los medicamentos para lograr un enfoque personalizado, dando suficiente tratamiento para mantener el tumor lo más pequeño posible, sin eliminar por completo a la población sensible.
Luego se retira la terapia. Esto permite que las células sensibles al tratamiento sigan luchando por espacio dentro del tumor, evitando que otras células resistentes a los medicamentos dominen debido a una ventaja adaptativa.
"Dado que no podemos controlar las células tumorales que son resistentes a la terapia, necesitamos reclutar células sensibles al tratamiento para que lo hagan por nosotros", dice Gatenby, quien ha estado desarrollando la idea desde que la publicó por primera vez en 1991 .
La esperanza, dice, es que los médicos puedan mantener a los pacientes con vida durante un largo período de tiempo.
Su grupo de investigación, que es posiblemente el más avanzado en este campo, ya ha demostrado que esta técnica funciona en un pequeño ensayo piloto en el que participaron pacientes con cáncer de próstata. Los pacientes que recibieron terapia adaptativa también tuvieron una supervivencia general 2,26 años mayor que aquellos que recibieron el tratamiento estándar.
Con la otra terapia, la de extinción, Gatenby quiere ir un paso más allá y utilizar lo que sabemos sobre cómo se extinguen las especies animales para diseñar terapias curativas que provoquen la extinción de las poblaciones de cáncer.
La idea sería no esperar a que el tumor vuelva a crecer después de que los médicos apliquen la terapia inicial, sino más bien aplicar al tumor una terapia completamente diferente antes de que pueda recuperarse: tomar por sorpresa a las células tumorales con un ciclo rápido de un medicamento diferente.
Aunque, hasta ahora, solo hay un modelo matemático de esta terapia, el equipo de Gatenby ha propuesto ensayos clínicos contra el cáncer de páncreas y el cáncer de mama.
Fuente de la imagen, Getty Images
El elefante en la habitación sigue siendo cómo una investigación como esta pasará de los ensayos clínicos, si tiene éxito, a la aceptación en el mundo real, según Michael E Hochberg, distinguido director de investigación del Centro Nacional de la Recherche Scientifique de la Universidad de Montpellier, en Francia.
"¿Cuál es su uso realista, en términos de utilidad?", se pregunta.
Tal vez la medicina evolutiva sea realmente la perspectiva científica más probable para abordar grandes cuestiones como estas, según Hochberg, pero los médicos todavía tienen que tratar a los pacientes todos los días trabajando con soluciones que conocen, mejores prácticas probadas y poco espacio para hipótesis:
"Tienen el deber de 'primero no hacer daño'", afirma, y en este momento estos hallazgos son todavía demasiado preliminares.
Una solución a las bacterias resistentes
La medicina evolutiva también se aplica en la búsqueda de una solución a uno de los problemas de más rápido crecimiento en el mundo moderno: la resistencia a los antibacterianos.
El uso generalizado de antibióticos ha llevado inadvertidamente a las bacterias a evolucionar y crear resistencia. Además, las bacterias también desarrollan resistencia de otros modos, desde el intercambio de material genético hasta acumulando mutaciones aleatorias.
Como resultado, los científicos evolutivos están probando varios enfoques diferentes para descomponer estas vías.
"Si queremos resolver este problema, necesitamos entender la evolución y luego ir tras los puntos débiles", dice Andrew Read, director de los Institutos Huck de Ciencias de la Vida de la Universidad Penn State.
El equipo de Read está desarrollando "fármacos antibióticos" para ayudar a controlar la propagación de la resistencia a los antimicrobianos en lugares donde los fármacos pueden hacer más mal que bien.
Por ejemplo, la resistencia a los antimicrobianos suele ocurrir porque algunos de los antibióticos potentes que los pacientes reciben por vía intravenosa llegan al sistema digestivo del paciente, allí cambian el equilibrio de la microbiota y, como resultado, se crea resistencia a los medicamentos.
Los medicamentos de inactivación, en sí mismos, no hacen nada clínicamente, pero impiden que el medicamento actúe en el intestino y podrían reducir este efecto pernicioso.
Su laboratorio ya ha demostrado que este mecanismo funciona bien en ratones para prevenir la propagación de la superbacteria Enterococcus faecium después del tratamiento con antibióticos.
Pero esta es una solución general que no inhibe la resistencia en caso de que se encuentren bacterias y medicamentos.

Fuente de la imagen, Getty Images
Una de las razones por las que la resistencia bacteriana es tan difícil de abordar es que no ocurre simplemente a través de la típica ruta evolutiva impulsada por el azar: cuando una mutación aleatoria hace que algunas bacterias sean más fuertes y capaces de resistir los medicamentos.
También ocurre gracias a la transferencia horizontal de genes, algo que sucede tanto dentro de la misma especie de bacteria como entre especies. Este proceso permite que las mutaciones que transmiten resistencia a los medicamentos se propaguen mucho más rápidamente.
El grupo de investigación de Anne Farewell de la Universidad de Gotemburgo, Suecia, está intentando frenar uno de los mecanismos que utilizan las bacterias para compartir el ADN de forma horizontal, conocido como "conjugación”, donde las células entran en contacto directo, a menudo a través de un tubo que corre entre ellas.
En su investigación, los científicos observan qué pares de especies bacterianas se mezclan y si hay condiciones ambientales específicas, como pesticidas o contaminación por metales pesados, que faciliten o dificulten esto.
Ya han demostrado que la Escherichia coli, una bacteria común que puede causar intoxicación alimentaria y una amplia gama de otras infecciones, podría frenar la conjugación al entrar en contacto con el cobre, lo que reduce su capacidad de conjugación casi 100 veces.
"Comprender qué moléculas arruinan la conjugación podría ayudar a desarrollar 'fármacos anti-conjugación' efectivos, pero la investigación aquí aún es preliminar, y todavía hay muchas otras formas en que se puede compartir el ADN entre bacterias a las que este enfoque no afectará", admite Farewell.
Las bacterias son increíblemente inteligentes, dice. "No creo que vaya a haber una solución. Habrá muchos enfoques".
Un dilema entre académicos y médicos
Si bien los campos de la investigación del cáncer y la resistencia bacteriana son los más avanzados en el campo de la medicina evolutiva, todavía queda un largo camino por recorrer.
Los críticos argumentan que a pesar de comprender más sobre la teoría de la medicina evolutiva, no está claro hasta qué punto este nuevo conocimiento se puede utilizar en la práctica.
"Rara vez he visto conversaciones que realmente se centren en el problema de la logística y los beneficios del traslado del banco a la clínica", afirma Hochberg.
También hay fricciones entre intelectuales y entre lo que piensan los académicos darwinianos y los médicos.
"El principal desafío es cerrar la brecha entre los académicos que trabajan en biología evolutiva, la formación de los médicos y la mentalidad del médico en el contexto de todo el establishment de las grandes compañías farmacéuticas”, apunta dice Bernard Crespi , biólogo evolutivo de la Universidad Simon Fraser.
También sigue siendo un gran interrogante cómo la medicina evolutiva encontrará una manera de colaborar con la industria farmacéutica.
Pero Nesse –el hombre que inició todo– dice que la medicina evolutiva todavía tiene el poder de proporcionar nuevas preguntas y nuevas respuestas sobre las enfermedades:
"Existe un abismo entre la biología evolutiva y la medicina y en realidad está dañando la salud humana", dice Nesse. "Es un proceso lento, pero la ciencia siempre gana".

Recuerda que puedes recibir notificaciones de BBC News Mundo. Descarga la última versión de nuestra app y actívalas para no perderte nuestro mejor contenido.












